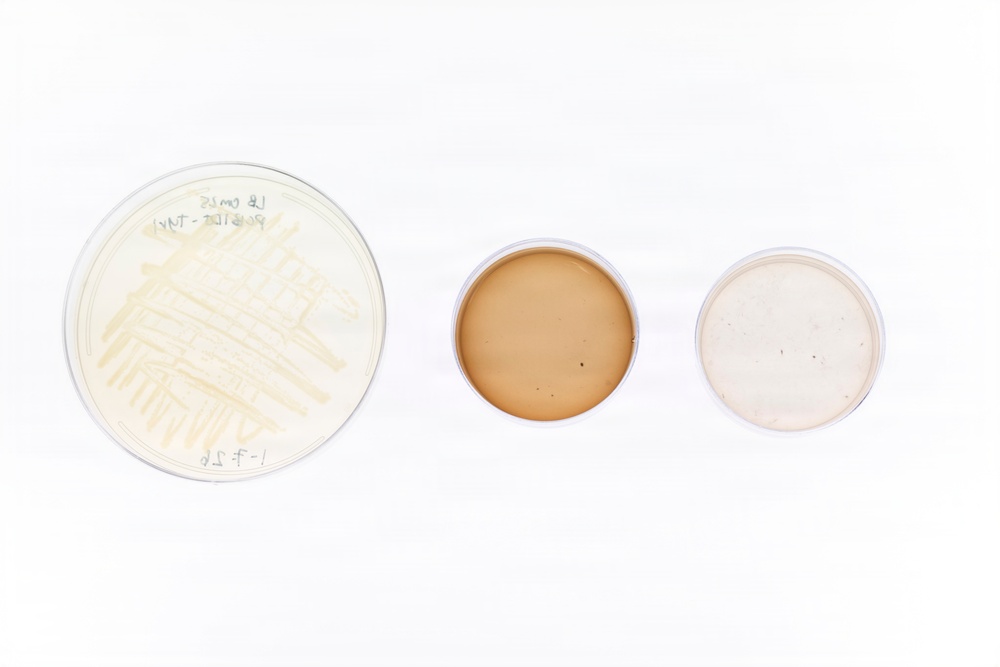
Microbial Biomanufacturing

Microbial samples for the Melanized Microbes for Multiple Uses in Space experiment sit on display in Washington, D.C., Jan. 9, 2026. U.S. Naval Research Laboratory scientists participated in the experiment and sent samples aboard the International Space Station to investigate how microgravity affects microbial metabolism and biomaterial production. (U.S. Navy photo by Sarah Peterson)
| Date Taken: | 01.09.2026 |
| Date Posted: | 01.22.2026 10:57 |
| Photo ID: | 9487669 |
| VIRIN: | 260109-N-CZ309-1004 |
| Resolution: | 7159x4773 |
| Size: | 1.8 MB |
| Location: | WASHINGTON, DISTRICT OF COLUMBIA, US |
| Web Views: | 21 |
| Downloads: | 1 |

This work, Microbial Biomanufacturing [Image 5 of 5], by Sarah Peterson, identified by DVIDS, must comply with the restrictions shown on https://www.dvidshub.net/about/copyright.